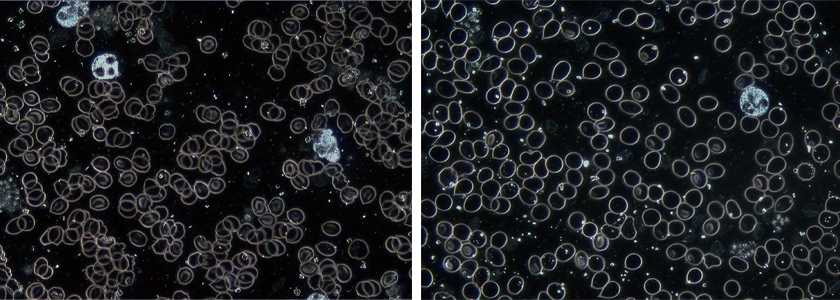

【Vol.4】自己治癒力を最大限に発揮させる治療とは
2023-04-14
自己治癒力を最大限に発揮させる治療をしています
水素ガス吸入機を活用する医師や研究者にお話しをお伺いする「ドクターズインタビュー」。
第4回は、岡崎ゆうあいクリニックの小林正学院長にインタビューをしました。
(取材日2022年3月)
ドクタープロフィール

岡崎ゆうあいクリニック
小林正学院長
国際水素医科学研究会 監事
長年がんに対する免疫を誘導する樹状細胞ワクチン療法に携われ、また治療効果を高めるため水素ガス吸入療法を採用。4月6日に愛知県岡崎市で岡崎ゆうあいクリニックを開業。
ドクターズインタビュー
開院されたクリニックの方針や特徴をお聞かせください。
患者さんに寄り添いながら、内科、皮膚科、小児科などの西洋医学だけでなく、統合医療、がん治療を提供していこうと思っています。その場しのぎの薬を処方するのではなく、病気の根本原因を探求して、患者さんの治ろうとする力を最大限に発揮できる医療を提供しながら、患者さんが幸せに生きていけるようにお手伝いをしたいです。病気は私達が幸せに生きるヒントを教えてくれますので、病気が伝えてくれているメッセージに医師として耳を傾けながら診療をしていきたいと考えています。
先生がされている『感性医療』とは、どのような治療ですか?
私は2019年に自分自身が甲状腺がんとなり、がん患者となりました。これまでは先端医療、西洋医学を重視していましたが、自分ががんになった時に、これまでの医療に限界を感じて、全国の統合医療の医師やがんのサバイバー、そして、一流の治療家から学ぶようになりました。奇跡的ながんのサバイバーと会っていると、大きな心の変化があった人が多く、病気が本当に癒されるには心が癒されることが大切だとわかってきました。
それから私は岡部明美さんから心の学びをして「感性」の大切さを知り、私は人間の感性を大切にした医療を「感性医療」と名付けました。私の目指す感性医療とは、人間の感性を大事にして自分自身を取り戻しながら、本当の自分の人生を生き切るお手伝いをする医療のことです。実際には本人も意識していない患者さんの心の問題に医師の私が気づいて拾い上げ、可能な範囲内で心のワークを実践し、必要と感じたら積極的にプロのカウンセラーに紹介しています。
どんなに良い医療があったとしても、やはり救えない人たちは沢山いるのは事実です。でも、私は大切なことは命の長さではないと思うようになりました。心が満たされない状況で不平不満、苦しみなど色々なネガティブな感情を持ったまま、そこで5年、10年生きたとして、本当に幸せなのだろうかと…。それよりも、本当の自分と巡り合い、心が満たされて3か月生きた方が私は幸せだと思うのです。もちろん、私は医師ですので最善を尽くして良好な経過を辿れるように努力をしますが、人間の寿命はあります。残された命が輝き、幸せに満ちた日々になるように私医師もお手伝いをしていくことができれば素晴らしいですね。
私には一つの夢があります。それはがんと診断されたら、岡部明美さんの仲間たちのカウンセリングを全ての人が受けられるようにすることです。私を含めて医師は、がんの告知をするときに、手術日の相談はしますが、患者さんの衝撃を受けた心の傷を癒してきませんでした。私は手術日の相談だけでなく、主治医がカウンセリングの紹介もする世の中にしていきたいと思っています。
水素吸入療法を始めた理由と、どのような方に勧めていますか?
水素ガス吸入療法を初めて知ったのは2018年に、ある患者さんから水素ガス吸入療法ががんに効く可能性があると教えてもらったことがキッカケでした。自分で水素吸入を試してみると吸入中はリラックスできて眠くなります。その後、萬憲彰先生(よろずクリニック)が全例のがん患者さんへ水素を勧めていることを知り、さらに赤木純児先生(くまもと免疫統合医療クリニック)が見事なデータ集積により水素ガス吸入療法ががん治療に有効であることを示され、水素に対する認識が徐々に変わってきました。
現在は特に全身状態が不良の方に積極的におすすめしています。倦怠感が強いとか体の調子がすごく悪い方、抗がん剤の副作用で苦しんでいるような人は水素吸入の体感を得やすいからです。開業後は花粉症や喘息、不安神経症、皮膚炎、糖尿病、自己免疫性疾患などの患者さんにも勧めています。

水素の活用方法と有用についてお聞かせください。
私のところへ来られた、ある肺がんの患者さんで初診の時に抗がん剤の副作用で「もう、しんどくてしんどくて堪らないから、とにかく何とかして欲しい。」と言っていた方が、水素ガス吸入とAWG治療を両方おこなうと、1時間で著しくに改善して穏やかな表情で帰宅されました。
その患者さんの経験から、しんどい時には水素吸入は本当に良いと感じました。がんが進行して、抗がん剤の副作用で苦しんでいる人ほど水素ガス吸入療法で自覚症状の改善がみられるようです。逆に比較的元気な方には体感が得られにくいこともわかっています。極限まで身体を酷使したスポーツ選手に水素吸入療法の効果が体感しやすいことにも納得です。
では、なぜ状態が悪い人が効果を実感しやすいのでしょうか?赤木純児先生はご自身の論文の中で、水素は疲弊したキラー細胞を活性化した状態へ戻すことができると報告していますし、これまでの論文では水素はミトコンドリア機能を回復させることも報告されています。私は水素のもう一つ非常に重要な役割として「抗炎症作用」にも注目するようになりました。
炎症に対して、水素はどのような作用があるのでしょうか?
私は10年以上にわたり樹状細胞ワクチン療法をはじめとした免疫治療に携わり、これまで多くの免疫の専門家と議論してきた中で、「がんの炎症」は最大のポイントでした。炎症により免疫が抑制されてしまうからです。がんの進行に伴って炎症は悪化していくのですが、炎症が進むと免疫抑制細胞が増加して免疫抑制状態に陥るため、どんなに免疫治療を行っても効果が得られなくなってしまいます。この炎症を克服するために過去にはセレコックスを処方していましたが、胃・十二指腸潰瘍などの副作用が出現したこともあり、徐々に使用しなくなりました。最近ではアクテムラ(IL-6阻害薬)の導入を検討したこともありますが、副作用もゼロではないので、やはり実現には至りませんでした。
一方、水素ガス吸入療法は副作用がなく炎症を抑制することのできる治療法です。水素の抗炎症作用の学術論文は世界からたくさん発表されていて、水素は炎症を拡大する炎症性サイトカインを減らすことは明らかになっています。副作用なく炎症を抑え込むことができる水素ガス吸入療法は、がん免疫に最適な治療ではないかと考えています。
もう一つ、水素の抗炎症作用による血液環境改善の可能性にも期待しています。末期がんの患者さんの血液を暗視野顕微鏡という特殊な顕微鏡で観察すると、①赤血球の連銭形成、②血漿に網状のフィブリン(フィブリンネット)が観察されます。これらが出現しますと、毛細血管を赤血球が通りにくくなりますので、低酸素状態になってがんが進行しやすい環境になるかもしれません。また、フィブリンネットがあると赤血球だけなく、免疫細胞もロックされて動けなくなるので、免疫治療の効果も得られにくくなるでしょう。
特にがんの進行が高度な方や、抗がん剤による副作用が顕著で全身状態が悪化している方では、かなりの高い頻度で観察されます。炎症反応と赤血球の連銭形成は密接な関係があると報告されているのですが、末期のがん患者さんは炎症が几進しているので赤血球の連銭形成がよく観察されます。もし、水素吸入で炎症反応が軽減できたら、このような血液環境が改善していくかもしれません。まだ、十分な検証はできていませんが、やや重なり気味だった赤血球が【写真(左)】、水素を1時間吸入すると綺麗にばらけています【写真(右)】。おそらく、長時間、高頻度で水素を吸入すると、もっと血液環境の改善がみられていくでしょう。
先生は、水素吸入で体感がありますか?
疲れた時に吸入すると身体がスッキリ回復します。残業の時は水素を吸いながら仕事をしています。院内でも手頃な価格で吸入できるスペースを用意していますので、皆さんにもしんどい時は、1時間吸って欲しいなと思います。
小林先生、ありがとうございました!
クリニックデータ

岡崎ゆうあいクリニック
住所:愛知県岡崎市筒針町字池田104-1 GoogleMap
TEL:0564-64-1722
受付時間:月・火・木・金 午前9:00~12:00 午後16:00~19:00 / 水・土 午前9:00~12:00
休診日:水・土曜日 午後 / 日曜日・祝日


